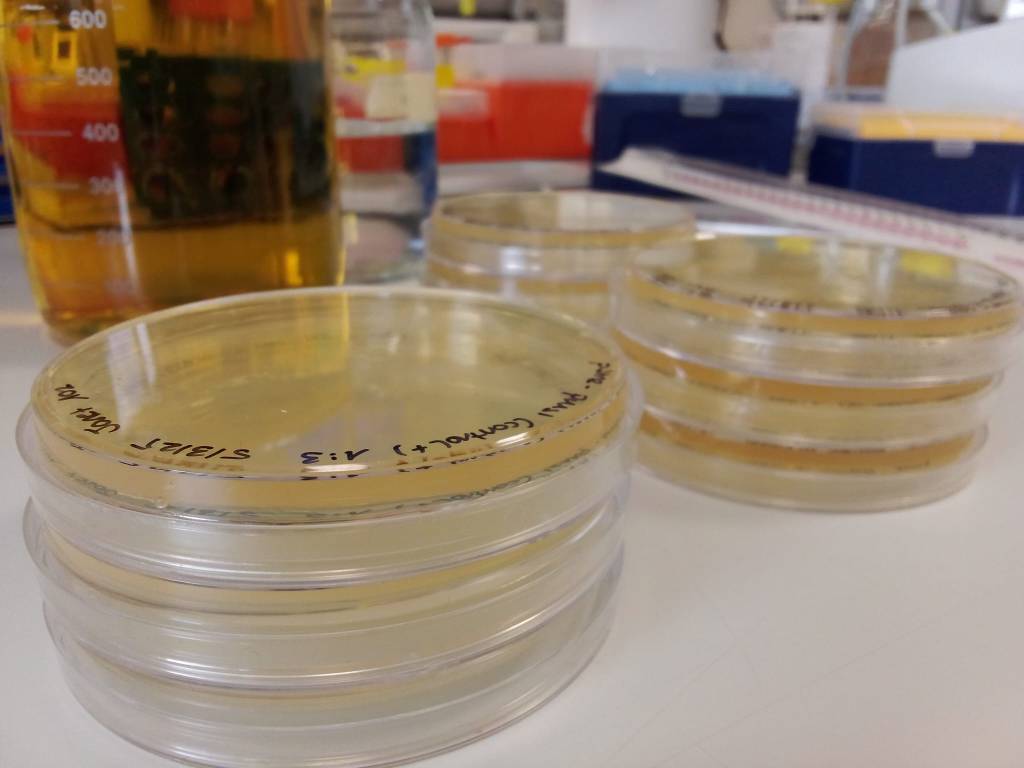

Our vision it to study the underlying molecular mechanisms of novel repeat expansions recently discovered in human disease. The main goal is to mechanistically dissect how repeat expansions disrupt gene and cellular function using an innovative and multidisciplinary approach that combines cell biology, biochemistry and long-read sequencing.

Repetitive sequences can be found throughout the human genome. These are prone to breakage, can interfere with DNA metabolism and are susceptible to expansion or contraction, leading to genomic instability.

Despite the latest advances in sequencing and other techniques, current studies lack mechanistic insights into the molecular processes driving these expansions and how they might disrupt gene and cellular function.
By studying its impact in cell physiology, genomic instability and gene expression, we aim to uncover the underlying mechanisms of repeat instability and in the long-term its broader implications in human health.





Manuel Daza Martín – Principal Investigator
ORCID LinkedIn
Meet the rest of our team
For any inquiry, please use the following contact details:
manuel.daza@ipb.csic.es
+34 958181667
Instituto de Parasitología y Biomedicina López-Neyra (IPBLN-CSIC)
Avda. del Conocimiento nº17
Granada, Spain
18016